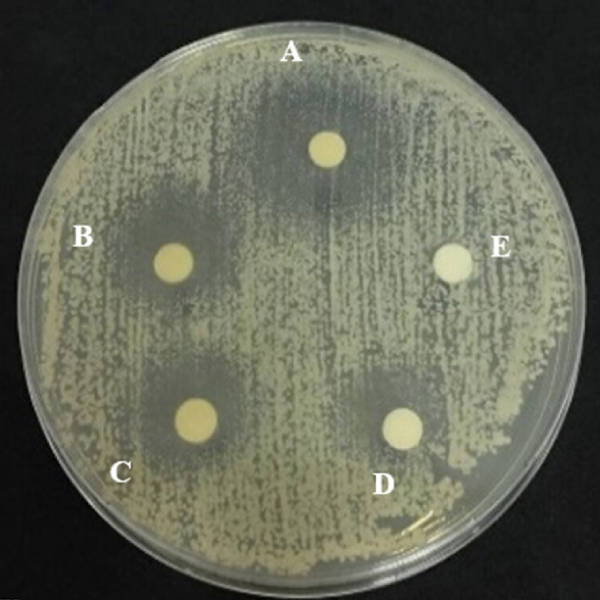

فروش سویه کاندیدا آلبیکنس کد ATCC 10231
شرکت اینترنتی تمادکالا از فروشندگان سوشهای باکتریایی پیشرو در جهت خدمت رسانی به مشتریان است. جهت اطلاع از خصوصیات سویه کاندیدا آلبیکنس کد ATCC 10231 می توانید بخش های بعدی را مشاهده نمایید.
کاندیدا آلبیکنس یکی از رایج ترین گونه قارچی در میکروبیوتای انسان است. همچنین شایعترین گونه قارچی تک سلولی جدا شده از بیوفیلمهای تشکیل شده روی دستگاههای پزشکی یا روی بافت انسان هست. این قارچ از گونههای کاندیدا است که منجر به عفونت های مخمری دردناک میگردد. در دستگاه گوارش نیز زندگی می کند. باکتری ها و سایر میکروارگانیسم هایی که میکروبیوم بدن را تشکیل می دهند، می توانند تعداد این گونه را کنترل کنند. با این حال از بین رفتن تعادل میکروبی تحت شرایط مختلف باعث رشد قارچ خارج از کنترل و باعث عفونت کاندیدیازیس انسانی میشود.
کاندیدا آلبیکنس ATCC 10231 یک سویه مرجع از قارچ مخمری کاندیدا آلبیکنس است. استاندارد اختصاص یافته توسط سازمان توسعه استانداردهای ATCC (مجموعه فرهنگ نوع آمریکایی) ایجاد شده است. توجه داشته باشید این استاندارد فقط برای استفاده تحقیقاتی بوده و برای مراکز درمانی و استفاده تشخیصی مناسب نمی باشد. این سویه برای استفاده در آزمایش های شرح داده شده در ASTM E97991 مناسب است.
خصوصیات سویه کاندیدا آلبیکنس کد ATCC 10231
- از دسته قارچهای کیسه ای
- مخمر بیضی و گرد
- عامل بیماری های قارچی
- گونه مخمر بیماری زا
- یک نوع قارچ و یک مخمردودیپلوییدی
- نگهداری در دمای 2 تا 8 درجه سلسیوس
کاربردهای سویه کاندیدا آلبیکنس کد ATCC 10231
کاربردهای این سویه بسیار زیاد است که مهم ترین آنها مواردی است که در ادامه به آن ها اشاره می شود.
- این سویه به عنوان مرجعی برای مطالعه خصوصیات کاندیدا آلبیکنس، فعالیتهای ضدقارچی و واکنشهای بیولوژیکی آن، به کار میرود.
- به عنوان یک میکروارگانیسم آزمایشی مفید در آزمایش ASTM E640 که آزمایش استاندارد برای مواد نگهدارنده در لوازم آرایشی حاوی آب است، کاربرد دارد.
- به عنوان یک میکروارگانیسم آزمایشی توصیه شده برای AENOR UNE-EN 1275 جهت بررسی فعالیت قارچکشی و مخمرکشی ضدعفونیکنندهها و گندزداهای شیمیایی استفاده می شود.
- میکروارگانیسم کاربردی برای ISO 11930 کاربرد دارد که برای ارزیابی محافظت ضدمیکروبی محصولات آرایشی استفاده می شود.
- در صنایع غذایی برای شمارش میکروارگانیسمهای شاخص یا عامل فساد در مواد غذایی و ترکیبات غذایی کاربرد دارد.
- برای ارزیابی اثرات ضدقارچی دهانشویه بر این سویهی استاندارد کاربرد دارد.
- در تحقیقات کشاورزی و کنترل کیفیت مورد استفاده قرار می گیرد.
- در تحقیقات مربوط به مقاومت ضد میکروبی، توسعه دارو و آزمایش محیط کشت به کار گرفته می شود.
- سنجش زون قارچی آمفوتریسین B و سنجش نگهدارندههای ضد میکروبی با این سویه انجام می شود.
- بررسی مکانیزم های عفونت و تشکیل بیوفیلم با این سویه انجام می گیرد.
- آزمایش فیلتر غشایی و آزمایش قارچکشها از کاربردهای دیگر آن است.
- در تولید DNA توپوایزومراز، آزمایش قارچکشها، نظارت بر محیط زیست، آزمایش اثربخشی نگهدارنده و آزمایش افزایش رشد کاربرد دارد.
- کاندیدا آلبیکانس در ترکیب با نانولولههای کربنی (CNT) برای تولید مواد بافتی نانوکامپوزیت زیستی رسانای الکتریکی پایدار استفاده شده است که به عنوان عناصر حسگر دما مورد استفاده قرار گرفتهاند.
محیط کشت مناسب
خرید سویه کاندیدا آلبیکنس کد ATCC 10231
فروشگاه اینترنتی تمادکالا آماده ارائه خدمات در زمینه فروش سویه کاندیدا آلبیکنس کد ATCC 10231 با قیمت مناسب به مشتریان است. در صورت داشتن هرگونه مشکل برای ثبت سفارش، با متخصصین مجموعه تمادکالا تماس حاصل فرمایید.